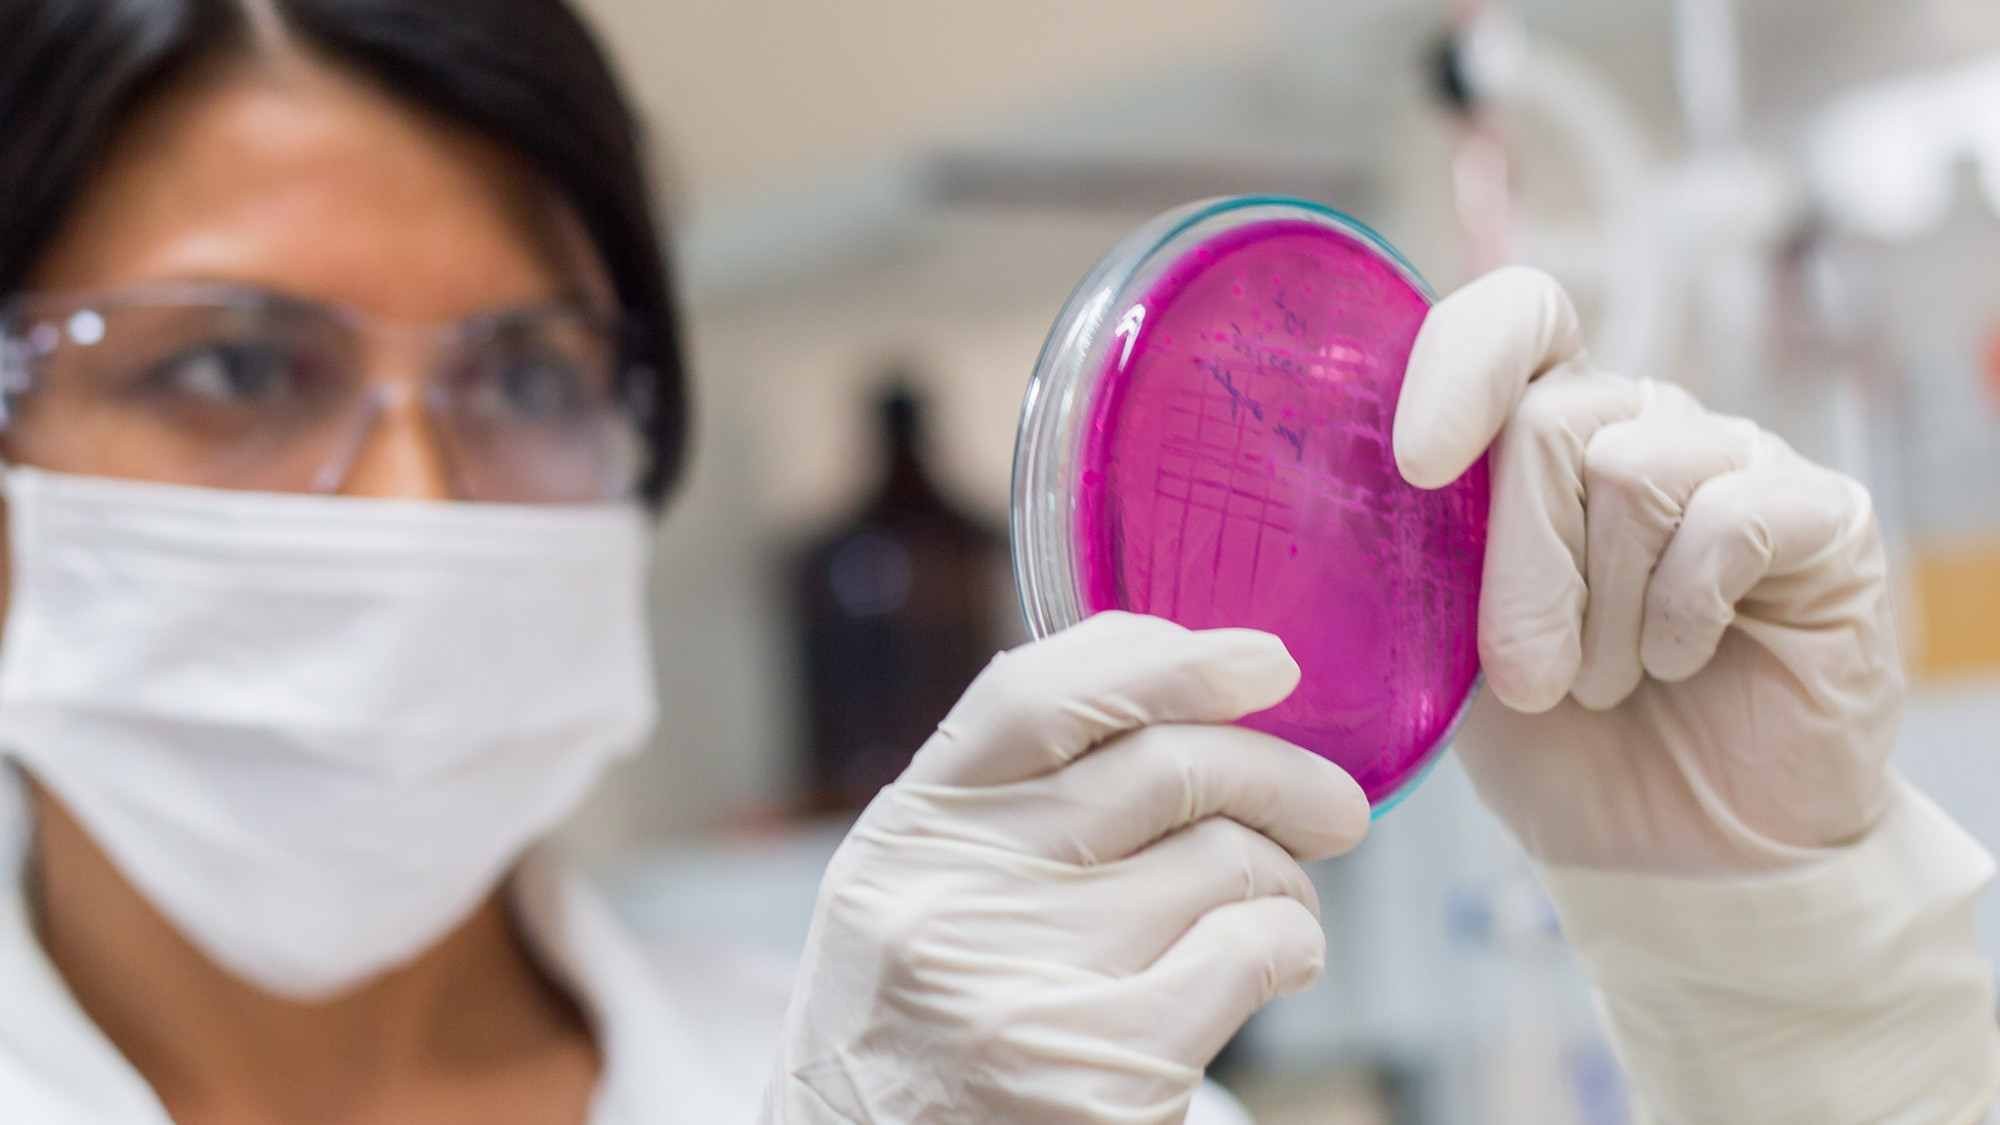

Isabel González, docente de la Facultad de Ingeniería, fue seleccionada para participar en el taller “Revalorando el rol de la mujer científica”, que se realizará en Lima el 15 y 16 de julio.
Por Lady Olivares. 05 junio, 2019.
El Encuentro nacional de mujeres científicas es organizado por la Academia Nacional de Ciencias (ANC) en coordinación con Punto Focal Peruano del Programa Mujeres para la Ciencia, en alianza estratégica con el Concytec. Entre sus objetivos, está la consolidación de la red de mujeres científicas nacionales, generada en los talleres de empoderamiento previos, efectuados en las diversas regiones del país.
A través de la interacción de las científicas representativas de otras realidades académicas de países vecinos, se propone incentivar el desarrollo académico y profesional en ciencia y tecnología de las miembros de los grupos de acción del Punto focal peruano (bases de datos y estadística; boletín digital, campaña de prensa y difusión; organización de eventos; y biografía de mujeres emblemáticas); y con las participantes que accedan a estas actividades.
Al respecto, la profesora Isabel González, docente de la Facultad de Ingeniería de la Universidad de Piura, precisa que a través de los talleres se busca, además, difundir y potenciar el desarrollo en ciencia y tecnología de las académicas de Perú. “Por eso, creo que será una oportunidad para conocer a otras investigadoras, no solo de mi área de estudio, que es la Estadística, sino también de otras distintas como las Ciencias sociales y Ciencias de la vida, que también se investigan en la Universidad de Piura”.
“Este acercamiento puede ser de ayuda para futuras colaboraciones o intercambios. Me siento honrada por haber sido invitada a participar en este Taller porque es un reconocimiento por el trabajo de investigación que realizo”, agrega.
Sobre los organizadores
La Academia Nacional de Ciencias integra la Red Interamericana de Academias de Ciencias (InterAmerican Network of Academies of Sciences – Ianas), que promueve y difunde la ciencia y tecnología. Forma parte de sus programas: Mujeres para la Ciencia, Educación y Ciencia, Agua, y Energía. Justamente, a través del Punto Focal Peruano de este programa, en alianza estratégica con el Concytec, la ANC ha venido realizando talleres de empoderamiento de la mujer científica peruana.
A la fecha, este esfuerzo conjunto ha resultado en cinco talleres, uno en Lima y cuatro descentralizados. Gracias a ellos, mujeres científicas se han incorporado a una red de interacción académica a nivel nacional. El Punto Focal Peruano del Programa Mujeres para la Ciencia, como integrante de la ANC, ha propuesto extender la interacción a los países vecinos, a través de las Academias de Ciencias de Bolivia, Chile y Ecuador.









